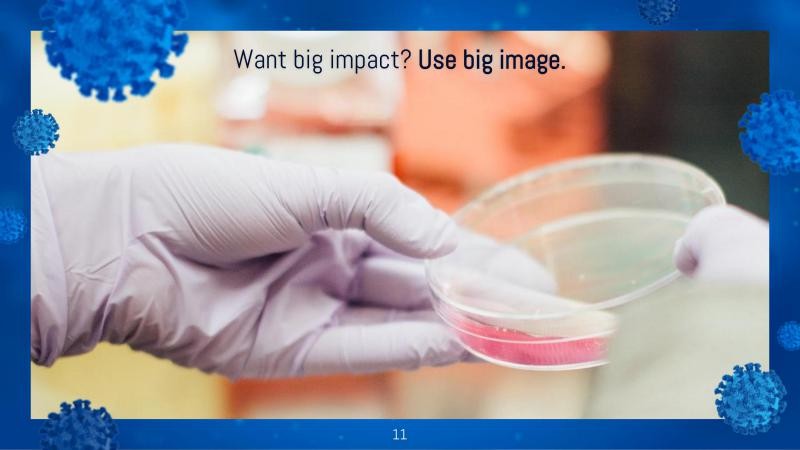
COVID Outbreak Presentation Template slide 11*352327

Mẫu PowerPoint COVID Outbreak Presentation Template: Giải pháp trình bày chuyên nghiệp
COVID Outbreak Presentation Template là một mẫu Powerpoint được thiết kế chuyên nghiệp, hướng đến các bài thuyết trình trong lĩnh vực y tế. Sự lựa chọn màu xanh lam chủ đạo mang đến cảm giác bình tĩnh, đáng tin cậy cho người xem.
Mẫu ppt này hoàn toàn miễn phí và cho phép người dùng tùy chỉnh mọi chi tiết theo nhu cầu.

Tính tương thích và ứng dụng
Mẫu thuyết trình dịch bệnh COVID Outbreak Presentation Template tương thích với cả Microsoft PowerPoint 2019 và Google Slides , mang lại sự linh hoạt tối đa cho người sử dụng.
Trong quá trình truyền tải các thông tin y tế, tính minh bạch và độ tin cậy là yếu tố then chốt. Thiết kế của mẫu PowerPoint này góp phần củng cố những yếu tố đó thông qua việc sử dụng màu xanh lam, tạo ấn tượng về sự chuyên nghiệp và phong cách làm việc đáng tin cậy.
Ưu điểm nổi bật
- Biểu tượng có thể tùy chỉnh: Dễ dàng điều chỉnh để phù hợp với nội dung trình bày.
- Bố cục đa dạng: Hỗ trợ thu hút sự chú ý của khán giả.
Bạn có thể ứng dụng mẫu PowerPoint này một cách tự tin trong các bài thuyết trình liên quan đến lĩnh vực chăm sóc sức khỏe, nghiên cứu y tế, các đợt bùng phát dịch bệnh hoặc các tình huống lâm sàng cụ thể.
COVID Outbreak Presentation Template là công cụ hỗ trợ đắc lực, giúp bạn truyền tải thông tin một cách hiệu quả và chuyên nghiệp.
Tải xuống Mẫu PowerPoint Trình Bày Dịch Bệnh COVID
- Hoàn toàn có khả năng tùy chỉnh bằng cách điều chỉnh màu sắc, nội dung văn bản và hình ảnh minh họa.
- Cung cấp hàng chục trang slide, kèm theo các gợi ý hữu ích để nâng cao chất lượng bài thuyết trình của bạn.
- Bạn có thể lựa chọn bố cục phù hợp nhất với thông tin cần trình bày, đồng thời dễ dàng thêm, xóa hoặc sắp xếp lại các slide theo yêu cầu cụ thể.
- Mẫu được thiết kế với tông màu xanh chuyên nghiệp, kết hợp hình ảnh liên quan đến virus.
- Bao gồm 60 biểu tượng y tế và hình ảnh minh họa về cơ thể người (nam, nữ, trẻ em, bé tập đi, mặt trước và mặt sau) để hỗ trợ giải thích hoặc báo cáo về các trường hợp bệnh tật.
- Cung cấp các ví dụ minh họa về cách trình bày đồ thị, biểu đồ và bảng số liệu.
- Bộ sưu tập 80 biểu tượng đa dạng và bản đồ thế giới được tích hợp sẵn.
- Có thể sử dụng với Google Slides hoặc tải xuống dưới dạng template PowerPoint để chỉnh sửa trực tiếp trên máy tính.
- Hỗ trợ xuất file ra nhiều định dạng khác nhau như PDF, JPG,...
- Định dạng màn hình trình chiếu rộng 16:9.
Mẫu PowerPoint này là công cụ hỗ trợ đắc lực cho việc trình bày thông tin về dịch bệnh COVID một cách chuyên nghiệp và dễ hiểu.
Ưu điểm nổi bật của mẫu
- Dễ dàng tùy chỉnh: Thay đổi mọi yếu tố thiết kế để phù hợp với nhu cầu của bạn.
- Tiết kiệm thời gian: Không cần thiết kế từ đầu, chỉ cần chỉnh sửa nội dung.
- Trực quan sinh động: Sử dụng hình ảnh và biểu tượng minh họa hấp dẫn.
Với mẫu PowerPoint này, bạn có thể tạo ra một bài thuyết trình ấn tượng và hiệu quả về dịch bệnh COVID.

Xem thêm: Mẫu PowerPoint Covid: Slide thuyết trình dịch bệnh COVID chuyên nghiệp .





















